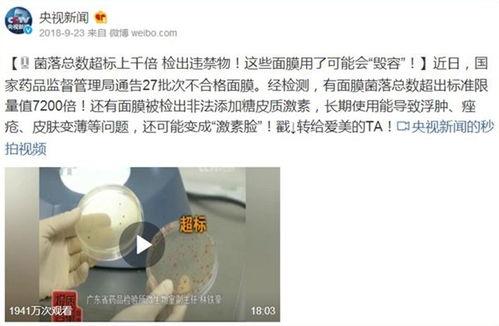

护肤品新闻爆料,热门产品真实效果大起底!
- 娱乐头条
- 2025-09-22
- 36
最近护肤品界可是热闹非凡呢!各大品牌纷纷推出新品,而一些护肤品的新闻爆料更是让人瞠目结舌。今天,就让我带你一起揭开这些护肤品的神秘面纱,看看它们背后的真相吧!
一、明星同款护肤品,真的有效吗?
还记得那个火爆全网的明星同款护肤品吗?它凭借明星效应,迅速成为了护肤界的爆款。真的有效吗?让我们来一探究竟。
据《中国消费者报》报道,明星同款护肤品往往价格不菲,但实际效果却并不理想。许多消费者在使用后,发现并没有达到预期的效果,甚至出现了皮肤过敏等问题。专家表示,明星同款护肤品并非万能,消费者在购买时应理性对待,不要盲目跟风。
二、网红护肤品,真的安全吗?

随着社交媒体的兴起,网红护肤品也成为了热门话题。这些产品凭借网红的推荐,迅速走红。但它们真的安全吗?
据《健康时报》报道,一些网红护肤品存在安全隐患。部分产品成分不明,甚至含有禁用成分。此外,由于缺乏监管,一些网红护肤品的生产环境堪忧。专家提醒,消费者在购买网红护肤品时,要仔细查看产品成分和生产厂家,确保安全。
三、护肤品广告,真的可信吗?

护肤品广告总是让人眼花缭乱,各种功效让人心动。但你是否想过,这些广告真的可信吗?
据《中国消费者协会》调查,部分护肤品广告存在夸大宣传、虚假宣传等问题。一些产品声称具有“神奇”功效,但实际上并无科学依据。专家表示,消费者在购买护肤品时,要理性看待广告,不要被夸大宣传所迷惑。
四、如何选择适合自己的护肤品?
面对琳琅满目的护肤品,如何选择适合自己的产品呢?
1. 了解自己的肤质:油性、干性、混合性、敏感性,不同肤质需要不同的护肤品。
2. 关注产品成分:选择成分安全、无刺激的产品。
3. 尝试试用装:在购买前,可以先尝试试用装,了解产品是否适合自己的皮肤。
4. 咨询专业人士:在选购护肤品时,可以向美容师、皮肤科医生等专业人士咨询。
五、护肤品的正确使用方法
护肤品虽然重要,但正确的使用方法同样关键。以下是一些护肤品的正确使用方法:
1. 清洁:使用温和的洁面产品,彻底清洁面部。
2. 保湿:涂抹保湿霜,为皮肤补充水分。
3. 美白:使用美白产品,改善肤色。
4. 防晒:涂抹防晒霜,保护皮肤免受紫外线伤害。
5. 睡眠:保证充足的睡眠,让皮肤得到充分休息。
护肤品的选择和使用是一门学问。只有了解自己的肤质,选择合适的产品,并正确使用,才能让皮肤焕发出健康光彩。让我们一起揭开护肤品的神秘面纱,拥抱美丽吧!























